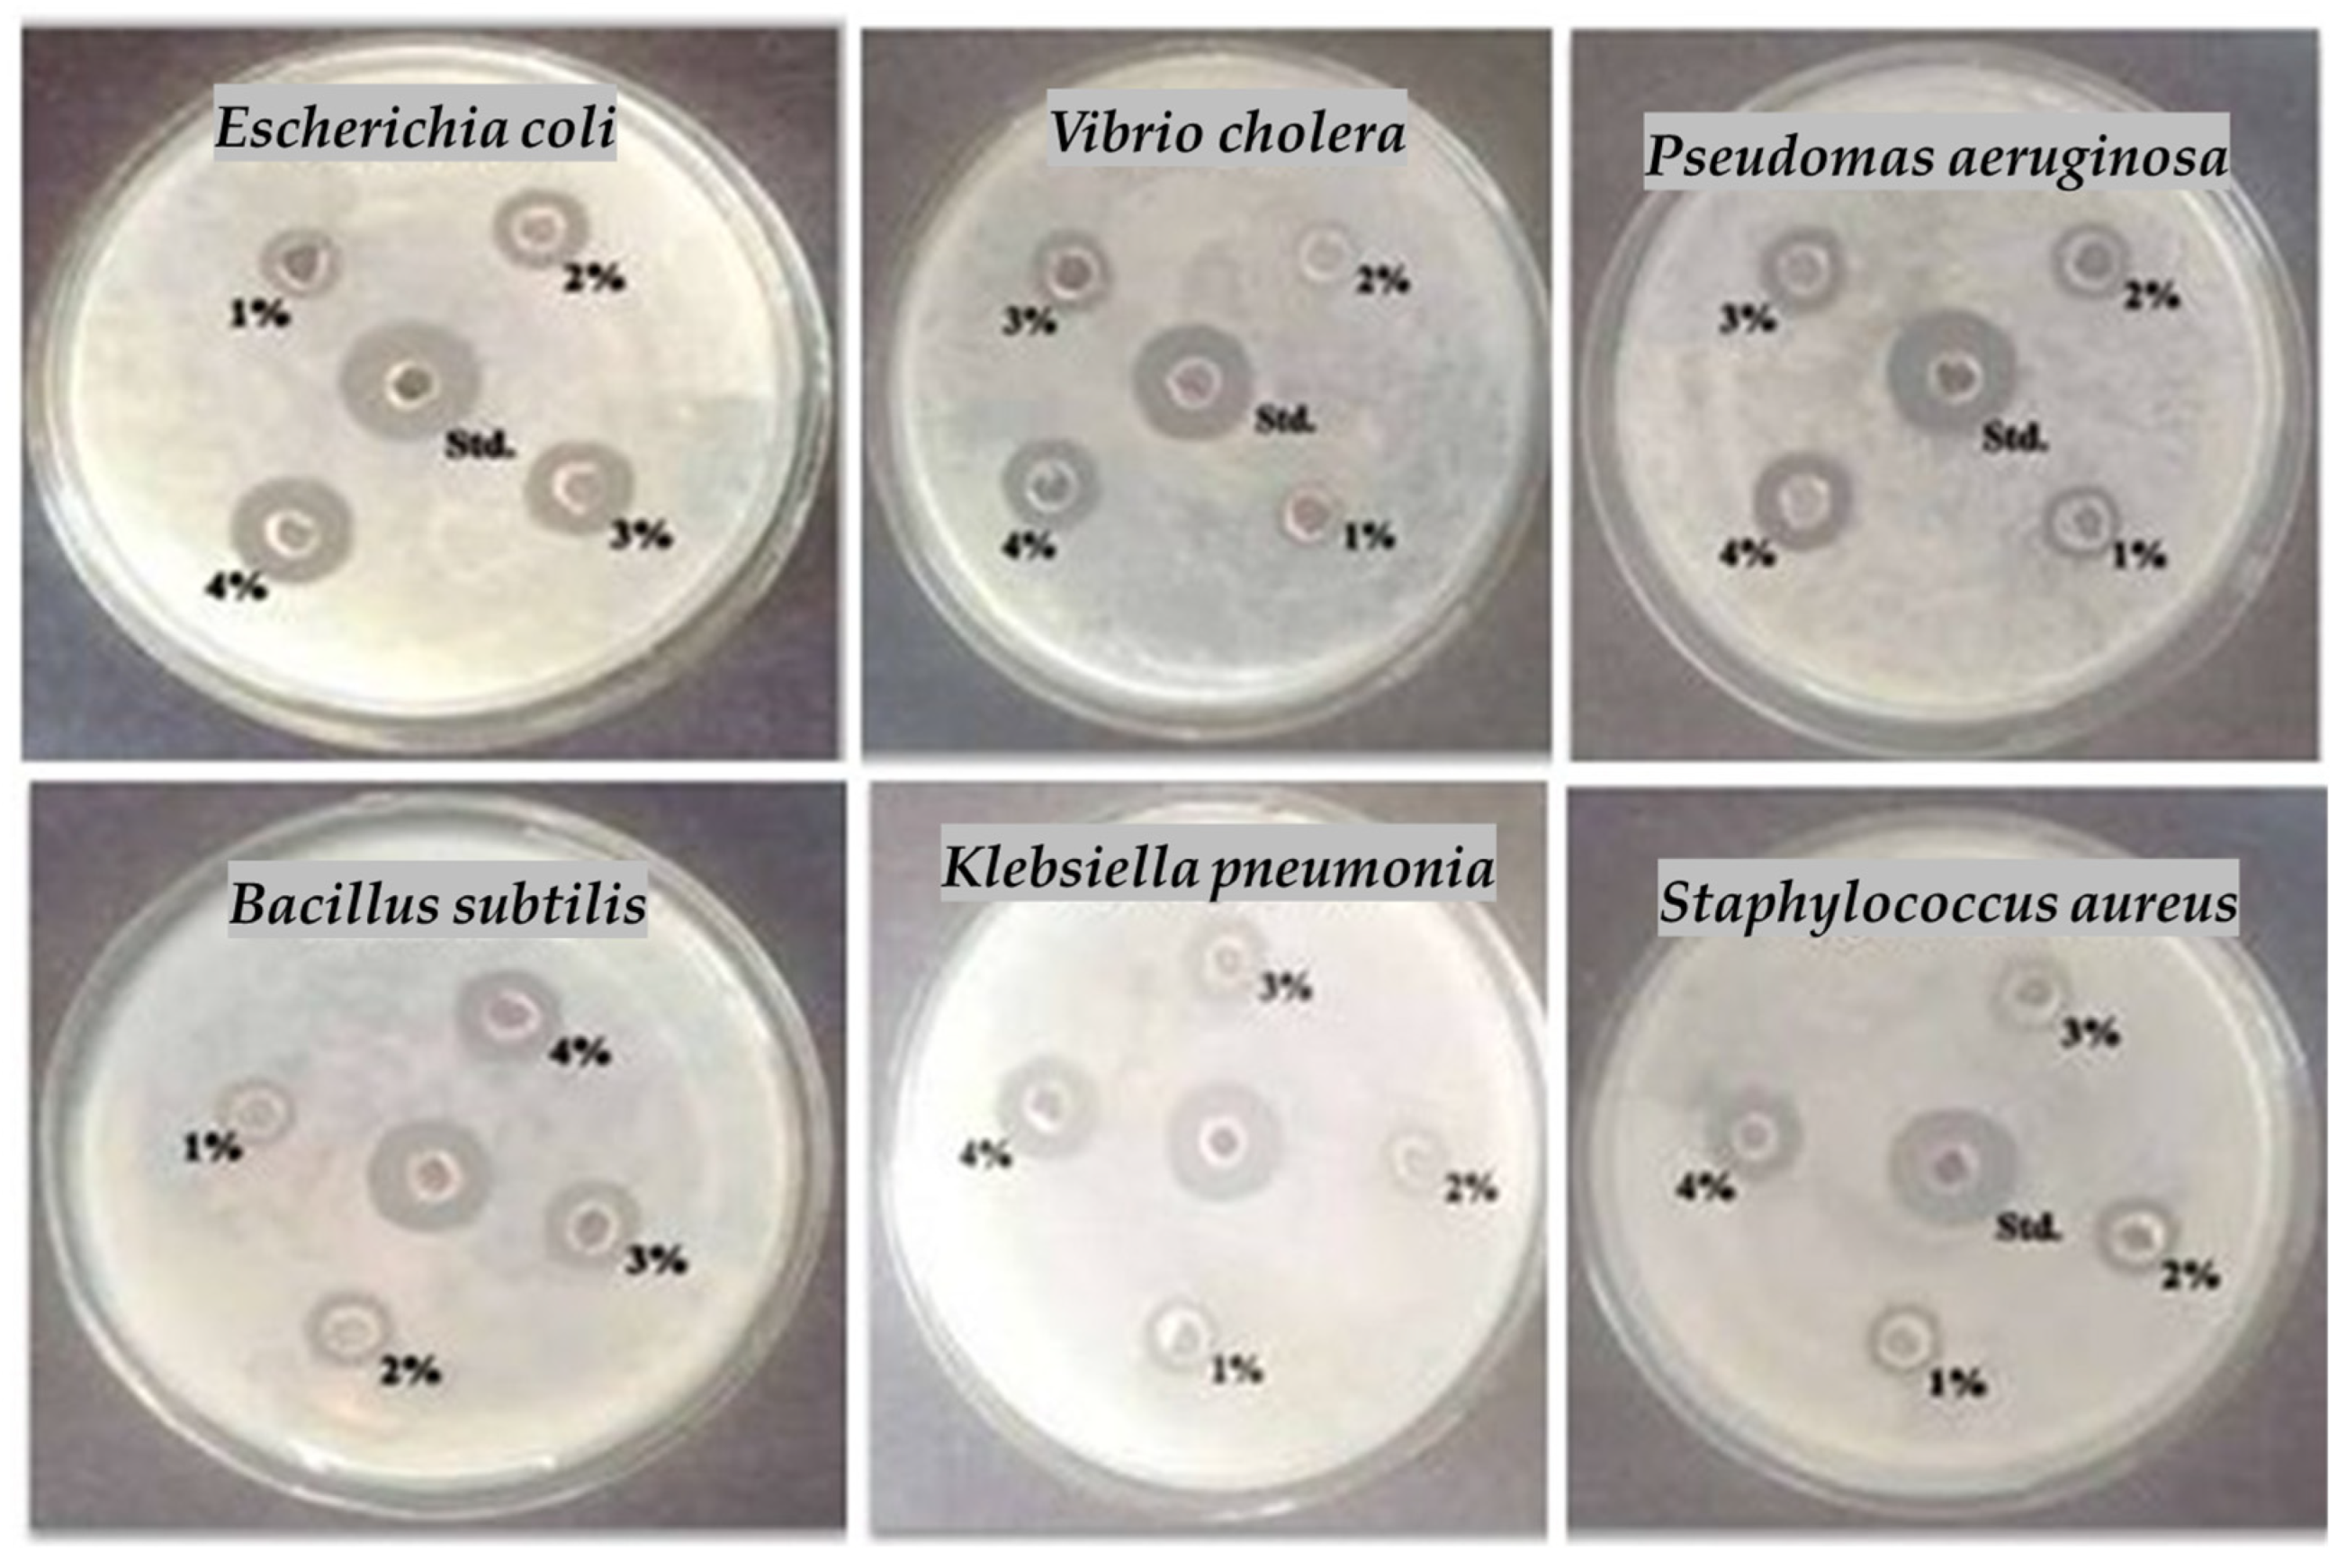
Marinedrugs 23 00224 g005

Exploration of Bioactive Compounds, Antioxidant and Antibacterial Properties, and Their Potential Efficacy Against HT29 Cell Lines in Dictyota bartayresiana
Abstract
1. Introduction
2. Results and Discussion
2.1. Phytochemicals Screening
2.2. Quantitative Analysis (Determination of Compounds)
2.3. Thin-Layer Chromatography
2.4. Column Chromatography
2.5. GC-MS Evaluation
2.6. HP-TLC Profile
3. Methodology
3.1. Preparation of Extract and Identification
3.2. Screening of Phytochemical Compounds
3.3. Quantitative Analysis
3.3.1. Estimation of Protein
3.3.2. Estimation of Flavonoids
3.3.3. Estimation of Tannins
3.3.4. Estimation of Total Ash
3.3.5. Estimation of Total Fat
3.3.6. Estimation of Total Carbohydrates
3.4. Thin-Layer Chromatography
3.5. Refinement of Active Compounds
3.6. Gas Chromatography–Mass Spectroscopy
3.7. Preparative HPTLC
3.8. Preparation of Sample
3.8.1. Nitric Oxide Scavenging Activity Analysis
Procedure
3.8.2. Hydrogen Peroxide Decomposition Activity
3.8.3. ABTS Scavenging Assay
3.9. Antibacterial Activities
3.10. Cytotoxicity Study by MTT Assay
3.11. Statistical Study
4. Conclusions
Supplementary Materials
Author Contributions
Funding
Institutional Review Board Statement
Informed Consent Statement
Data Availability Statement
Conflicts of Interest
References
- Shanahan, T. The Evolution of Darwinism: Selection, Adaptation and Progress in Evolutinary Biology; Cambridge University Press: Cambridge, UK, 2004. [Google Scholar]
- Generalić Mekinić, I.; Skroza, D.; Šimat, V.; Hamed, I.; Čagalj, M.; Popović Perković, Z. Phenolic content of brown algae (Pheophyceae) species: Extraction, identification, and quantification. Biomolecules 2019, 9, 244. [Google Scholar] [CrossRef] [PubMed]
- Bhatla, S.C.; Lal, M.A. Secondary Metabolites. In Plant Physiology, Development and Metabolism; Springer Nature: Singapore, 2023; pp. 765–808. [Google Scholar] [CrossRef]
- Rocha, D.H.A.; Seca, A.M.L.; Pinto, D.C.G.A. Seaweed Secondary Metabolites In Vitro and In Vivo Anticancer Activity. Mar. Drugs 2018, 16, 410. [Google Scholar] [CrossRef]
- Durairaj, S.B.; Andiyappan, B.R. Screening of phytochemicals, antibacterial, antioxidant and anti-inflammatory activity of Dictyota barteyresiana seaweed extracts. Asian J. Biol. Life Sci. 2020, 9, 20–26. [Google Scholar] [CrossRef]
- Chellamanimegalai, P.; Deshmukhe, G.; Balange, A.K.; Layana, P. Unveiling the nutritional and antioxidant properties of brown algae resources (Dictyota J.V. Lamouroux) from the Bay of Bengal and Arabian Sea, Indian coast. Heliyon 2025, 11, e40693. [Google Scholar] [CrossRef]
- Wijesinghe, W.A.J.P.; Athukorala, Y.; Jeon, Y.J. Effect of anticoagulative sulfated polysaccharide purified from enzyme-assistant extract of a brown seaweed Ecklonia cava on Wistar rats. Carbohydr. Polym. 2011, 86, 917–921. [Google Scholar] [CrossRef]
- Imran, M.; Iqbal, A.; Badshah, S.L.; Sher, A.A.; Ullah, H.; Ayaz, M.; Mosa, O.F.; Mostafa, N.M.; Daglia, M. Chemical and Nutritional Profiling of the Seaweed Dictyota dichotoma and Evaluation of Its Antioxidant, Antimicrobial and Hypoglycemic Potentials. Mar. Drugs 2023, 21, 273. [Google Scholar] [CrossRef] [PubMed]
- Miyashita, K. Marine antioxidants: Polyphenols and carotenoids from algae. In Antioxidants and Functional Components in Aquatic Foods; Kristinsson, H.G., Ed.; Wiley-Blackwell: Oxford, UK, 2014; pp. 233–249. [Google Scholar] [CrossRef]
- Rengasamy, K.R.R.; Amoo, S.O.; Aremu, A.O.; Stirk, W.A.; Gruz, J.; Šubrtová, M.; Doležal, K.; Van Staden, J. Phenolic profiles, antioxidant capacity, and acetylcholinesterase inhibitory activity of eight south African seaweeds. J. Appl. Phycol. 2015, 27, 1599–1605. [Google Scholar] [CrossRef]
- Nunes, N.; Ferraz, S.; Valente, S.; Barreto, M.C.; Pinheiro de Carvalho, M.A. Biochemical composition, nutritional value, and antioxidant properties of seven seaweed species from the Madeira Archipelago. J. Appl. Phycol. 2017, 29, 2427–2437. [Google Scholar] [CrossRef]
- Dierick, N.; Ovyn, A.; De Smet, S. In vitro assessment of the effect of intact marine brown macro-algae Ascophyllum nodosum on the gut flora of piglets. Livest. Sci. 2010, 133, 154–156. [Google Scholar] [CrossRef]
- Lopez-Santamarina, A.; Miranda, J.M.; Mondragon, A.D.C.; Lamas, A.; Cardelle-Cobas, A.; Franco, C.M.; Cepeda, A. Potential Use of Marine Seaweeds as Prebiotics: A Review. Molecules 2020, 25, 1004. [Google Scholar] [CrossRef]
- Mehdinezhad, N.; Ghannadi, A.; Yegdaneh, A. Phytochemical and biological evaluation of some Sargassum species from Persian Gulf. Res. Pharm. Sci. 2016, 11, 243–249. [Google Scholar] [PubMed]
- Guo, J.; Sun, W.; Kim, J.P.; Lu, X.; Li, Q.; Lin, M.; Mrowczynski, O.; Rizk, E.B.; Cheng, J.; Qian, G.; et al. Development of tannin-inspired antimicrobial bioadhesives. Acta Biomater. 2018, 72, 35–44. [Google Scholar] [CrossRef] [PubMed]
- Sidana, J.; Singh, B.; Sharma, O.P. Saponins of Agave: Chemistry and bioactivity. Phytochemistry 2016, 130, 22–46. [Google Scholar] [CrossRef]
- Sytar, O.; Hemmerich, I.; Zivcak, M.; Rauh, C.; Brestic, M. Comparative analysis of bioactive phenolic compounds composition from 26 medicinal plants. Saudi J. Biol. Sci. 2018, 25, 631–641. [Google Scholar] [CrossRef] [PubMed]
- O’ Connor, J.; Meaney, S.; Williams, G.A.; Hayes, M. Extraction of Protein from Four Different Seaweeds Using Three Different Physical Pre-Treatment Strategies. Molecules 2020, 25, 2005. [Google Scholar] [CrossRef] [PubMed]
- Circuncisão, A.R.; Catarino, M.D.; Cardoso, S.M.; Silva, A.M.S. Minerals from Macroalgae Origin: Health Benefits and Risks for Consumers. Mar. Drugs 2018, 16, 400. [Google Scholar] [CrossRef]
- Bharathi, D.S.; Boopathyraja, A.; Nachimuthu, S.; Kannan, K. Green Synthesis, Characterization and antibacterial activity of SiO2–ZnO nanocomposite by Dictyota bartayresiana extract and its cytotoxic effect on HT29 Cell Line. J. Clust. Sci. 2022, 33, 2499–2515. [Google Scholar] [CrossRef]
- Hejna, M.; Dell’anno, M.; Liu, Y.; Rossi, L.; Aksmann, A.; Pogorzelski, G.; Jóźwik, A. Assessment of the antibacterial and antioxidant activities of seaweed-derived extracts. Sci. Rep. 2024, 14, 21044. [Google Scholar] [CrossRef]
- Kazlowska, K.; Hsu, T.; Hou, C.C.; Yang, W.C.; Tsai, G.J. Anti-inflammatory properties of phenolic compounds and crude extract from Porphyra dentate. J. Ethnopharmacol. 2010, 128, 123–130. [Google Scholar] [CrossRef]
- Namvar, F.; Tahir, P.M.; Mohamad, R.; Mahdavi, M.; Abedi, P.; Najafi, T.F.; Rahman, H.S.; Jawaid, M. Biomedical Properties of Edible Seaweed in Cancer Therapy and Chemoprevention Trials: A Review. Nat. Prod. Commun. 2013, 8, 1811–1820. [Google Scholar] [CrossRef]
- Pravin, R.; Dong, C.-D.; Praveenkumar, R.; Patel, A.K.; Pandey, A.; Baskar, G. Technoeconomic Assessment and Optimization of Algal Oil Extraction from Marine Macroalgae Dictyota bartayresiana Biomass. Algal Res. 2023, 76, 103319. [Google Scholar] [CrossRef]
- Bouraï, L.; Logez, M.; Laplace-Treyture, C.; Argillier, C. How Do Eutrophication and Temperature Interact to Shape the Community Structures of Phytoplankton and Fish in Lakes? Water 2020, 12, 779. [Google Scholar] [CrossRef]
- Cox, S.; Abu-Ghannam, N.; Gupta, S. An assessment of the antioxidant and antimicrobial activity of six species of edible Irish seaweeds. Int. Food Res. J. 2010, 17, 205–220. [Google Scholar]
- Ravichandran, P.; Rajendran, N.; Al-Ghanim, K.A.; Govindarajan, M.; Gurunathan, B. Investigations on evaluation of marine macroalgae Dictyota bartayresiana oil for industrial scale production of biodiesel through technoeconomic analysis. Bioresour. Technol. 2023, 374, 128769. [Google Scholar] [CrossRef]
- Nagarajan, S.; Mathaiyan, M. Emerging novel anti-HIV biomolecules from marine Algae: An overview. J. Appl. Pharm. Sci. 2015, 5, 153–158. [Google Scholar] [CrossRef]
- Aravind, S.; Barik, D.; Ragupathi, P.; Vignesh, G. Investigation on algae oil extraction from algae Spirogyra by Soxhlet extraction method. Mater. Today Proc. 2021, 43, 308–313. [Google Scholar] [CrossRef]
- Ghasemi, Y.; Rasoul-Amini, S.; Morowvat, M.H. Algae for the Production of SCP; Nova Science Publishers Inc.: Hauppauge, NY, USA, 2011; pp. 163–184. [Google Scholar]
- Rajendrasozhan, S.; Moll, H.E.; Snoussi, M.; Romeilah, R.M.; Shalaby, E.A.; Younes, K.M.; El-Beltagi, H.S. Phytochemical Screening and Antimicrobial Activity of Various Extracts of Aerial Parts of Rhanterium epapposum. Processes 2021, 9, 1351. [Google Scholar] [CrossRef]
- Harborne, J.B. Phytochemical Methods: A Guide to Modern Techniques of Plant Analysis; Chapman and Hall Ltd.: London, UK, 1973; pp. 49–188. [Google Scholar]
- Ghosal, M.; Mandal, P. Phytochemical screening and antioxidant activities of two selected ‘BIHI’ fruits used as vegetables in Darjeeling Himalaya. Int. J. Pharm. Pharm. Sci. 2012, 4, 567–574. [Google Scholar]
- Manjunatha, J.R.; Bettadaiah, B.K.; Negi, P.S.; Srinivas, P. Synthesis of quinoline derivatives of tetrahydrocurcumin and zingerone and evaluation of their antioxidant and antibacterial attributes. Food Chem. 2013, 136, 650–658. [Google Scholar] [CrossRef]
- Takahata, K.; Katsuki, H.; Kobayashi, Y.; Muraoka, S.; Yoneda, F.; Kume, T.; Kashii, S.; Honda, Y.; Akaike, A. Protective effects of selegiline and desmethylselegiline against N-methyl-D-aspartate-induced rat retinal damage. Eur. J. Pharmacol. 2003, 458, 81–89. [Google Scholar] [CrossRef]
- Gehrke, I.T.; Neto, A.T.; Pedroso, M.; Mostardeiro, C.P.; Da Cruz, I.B.; Silva, U.F.; Ilha, V.; Dalcol, I.I.; Morel, A.F. Antimicrobial activity of Schinus lentiscifolius (Anacardiaceae). J. Ethnopharmacol. 2013, 148, 486–491. [Google Scholar] [CrossRef] [PubMed]
- Huang, H.; Chen, A.Y.; Rojanasakul, Y.; Ye, X.; Rankin, G.O.; Chen, Y.C. Dietary compounds galangin and myricetin suppress ovarian cancer cell angiogenesis. J. Funct. Foods 2015, 15, 464–475. [Google Scholar] [CrossRef] [PubMed] [PubMed Central]
- Johnson, I.T. Phytochemicals and cancer. Proc. Nutr. Soc. 2007, 66, 207–215. [Google Scholar] [CrossRef] [PubMed]
- Gaige, S.; Djelloul, M.; Tardivel, C.; Airault, C.; Felix, B.; Jean, A. Modification of energy balance induced by the food contaminant T-2 toxin: A multimodal gut-to-brain connection. Brain Behav. Immun. 2014, 37, 54–72. [Google Scholar] [CrossRef]
- Rodriguez-Garcia, C.; Sanchez-Quesada, C. Dietary Flavonoids as Cancer Chemopreventive Agents: An Updated Review of Human Studies. Antioxidants 2019, 8, 137. [Google Scholar] [CrossRef]
- Yahfoufi, N.; Alsadi, N.; Jambi, M.; Matar, C. The Immunomodulatory and Anti-Inflammatory Role of Polyphenols. Nutrients 2018, 10, 1618. [Google Scholar] [CrossRef]
- Abotaleb, M.; Samuel, S.M.; Varghese, E.; Varghese, S.; Kubatka, P.; Liskova, A.; Busselberg, D. Flavonoids in Cancer and Apoptosis. Cancers 2018, 11, 28. [Google Scholar] [CrossRef]
- Chirumbolo, S.; Bjorklund, G.; Lysiuk, R.; Vella, A.; Lenchyk, L.; Upyr, T. Targeting Cancer with Phytochemicals via Their Fine Tuning of the Cell Survival Signaling Pathways. Int. J. Mol. Sci. 2018, 19, 3568. [Google Scholar] [CrossRef]
- Perez-Vizcaino, F.; Fraga, C.G. Research trends in flavonoids and health. Arch. Biochem. Biophys. 2018, 646, 107–112. [Google Scholar] [CrossRef]
- Gorlach, S.; Fichna, J.; Lewandowska, U. Polyphenols as mitochondria-targeted anticancer drugs. Cancer Lett. 2015, 366, 141–149. [Google Scholar] [CrossRef]
- Moraes, V.R.d.S.; Tomazela, D.M.; Ferracin, R.J.; Garcia, C.F.; Sannomiya, M.; Soriano, M.d.P.C.; Silva, M.F.d.G.F.d.; Vieira, P.C.; Fernandes, J.B.; Filho, E.R.; et al. Enzymatic inhibition studies of selected flavonoids and chemosystematic significance of polymethoxylated flavonoids and quinoline alkaloids in Neoraputia (Rutaceae). J. Braz. Chem. Soc. 2003, 14, 380–387. [Google Scholar] [CrossRef]
- Bharathi, D.S.; Boopathy Raja, A. In Silico Studies On Colon Cancer Against Hexadecane, Hexadecanoic Acid Methyl Ester and Quinoline, 1, 2-Dihydro-2, 2, 4-Trimethyl Compounds from Brown Seaweed. Int. J. Res. Pharm. Sci. 2020, 11, 1927–1935. [Google Scholar] [CrossRef]
- Keeling, C.I.; Slessor, K.N.; Higo, H.A.; Winston, M.L. New components of the honey bee (Apis mellifera L.) queen retinue pheromone. Proc. Natl. Acad. Sci. USA 2003, 100, 4486–4491. [Google Scholar] [CrossRef]
- Xiao, X.; Zou, J.; Fang, Y.; Meng, Y.; Xiao, C.; Fu, J.; Liu, S.; Bai, P.; Yao, Y. Fisetin and polymeric micelles encapsulating fisetin exhibit potent cytotoxic effects towards ovarian cancer cells. BMC Complement. Altern. Med. 2018, 18, 91. [Google Scholar] [CrossRef]
- Zheng, G.Q.; Kenney, P.M.; Zhang, J.; Lam, L.K. Inhibition of benzo[a]pyrene-induced tumorigenesis by myristicin, a volatile aroma constituent of parsley leaf oil. Carcinogenesis 1992, 13, 1921–1923. [Google Scholar] [CrossRef]
- Sun, J.-Q.; Xu, L.; Tang, Y.-Q.; Chen, F.-M.; Wu, X.-L. Simultaneous degradation of phenol and n-hexadecane by Acinetobacter strains. Bioresour. Technol. 2012, 123, 664–668. [Google Scholar] [CrossRef]
- Ito, Y.; Kamijima, M.; Nakajima, T. Di (2-ethylhexyl) phthalate-induced toxicity and peroxisome proliferator-activated receptor alpha: A review. Environ. Health Prev. Med. 2019, 24, 47. [Google Scholar] [CrossRef] [PubMed]
- Zhang, L.L.; Lin, Y.M. Tannins from Canarium album with potent antioxidant activity. J. Zhejiang Univ. Sci. B 2008, 9, 407–415. [Google Scholar] [CrossRef]
- Fawole, O.A.; Amoo, S.O.; Ndhala, A.R.; Light, M.E.; Finnie, J.F.; Van Staden, J. Anti-inflammatory, ant cholinesterase, antioxidant and phytochemical properties of medicinal plant used for pain-related ailments in South Africa. J. Ethnopharmacol. 2010, 127, 235–241. [Google Scholar] [CrossRef]
- Lin, Y.; Shi, R.; Wang, X.; Shen, H.M. Luteolin, a flavonoid with potential for cancer prevention therapy. Curr. Cancer Drug Targets 2008, 8, 634–646. [Google Scholar] [CrossRef]
- Amaral, S.; Mira, L.; Nogueira, J.; da Silva, A.P.; Florêncio, M.H. Plant extracts with anti-inflammatory properties approach for characterization of their bioactive compounds and establishment of structure- antioxidant activity relationships. Bioorg. Med. Chem. 2009, 17, 1876–1883. [Google Scholar] [CrossRef]
- Rajauria, G.; Abu-Ghannam, N. Isolation and Partial Characterization of Bioactive Fucoxanthin from Himanthalia elongata Brown Seaweed: A TLC-Based Approach. Int. J. Anal. Chem. 2013, 2013, 802573. [Google Scholar] [CrossRef]
- Joshi, V.K.; Joshi, A.; Dhiman, K.S. The Ayurvedic Pharmacopoeia of India; Part-II, Vol-I (Formulations); Ministry of Health and Family Welfare: New Delhi, India, 2007; Volume 239, p. 147. [Google Scholar]
- Al-Khayri, J.M.; Sahana, G.R.; Nagella, P.; Joseph, B.V.; Alessa, F.M.; Al-Mssallem, M.Q. Flavonoids as potential anti-inflammatory molecules: A review. Molecules 2022, 27, 2901. [Google Scholar] [CrossRef] [PubMed]
- Sadasivam, S. A Textbook of Biochemical Methods; New Age International: New Delhi, India, 2005; pp. 8–9. [Google Scholar]
- Yalçın, M.; Turgut, N.; Gökbulut, C.; Mermer, S.; Sofuoğlu, S.C.; Tari, V.; Turgut, C. Removal of pesticide residues from apple and tomato cuticle. Environ. Sci. Pollut. Res. 2022, 30, 15821–15829. [Google Scholar] [CrossRef] [PubMed]
- Özşirvan, G.; Yalçın, M.; Turgut, N.; Tari, V.; Turgut, C. Insights into the uptake, translocation, and accumulation dynamics of cyantraniliprole and thiamethoxam seed coating pesticides in maize plants. Environ. Sci. Pollut. Res. 2024, 31, 44900–44907. [Google Scholar] [CrossRef]
- Balamurugan, V.; Fatima, S.; Velurajan, S.A. guide to phytochemical analysis. Int. J. Adv. Res. Innov. Ideas Educ. 2019, 5, 236–245. [Google Scholar]
- Wagner, E.H. Organizing care for patients with chronic illness revisited. Milbank Q. 2019, 97, 659. [Google Scholar] [CrossRef]
- Musharraf, S.G.; Ahmed, M.A.; Zehra, N.; Kabir, N.; Choudhary, M.I.; Rahman, A.-U. Biodiesel production from microalgal isolates of southern Pakistan and quantification of FAMEs by GC-MS/MS analysis. Chem. Cent. J. 2012, 6, 149. [Google Scholar] [CrossRef]
- Wahyuni, D.K.; Nuha, G.A.; Atere, T.G.; Kharisma, V.D.; Tari, V.S.; Rahmawati, C.T.; Murtadlo, A.A.A.; Syukriya, A.J.; Wacharasindu, S.; Prasongsuk, S.; et al. Antimicrobial potentials of Pandanus amaryllifolius Roxb.: Phytochemical profiling, antioxidant, and molecular docking studies. PLoS ONE 2024, 19, e030534. [Google Scholar] [CrossRef]
- Badami, S.; Moorkoth, S.; Rai, S.R.; Kannan, E.; Bhojraj, S. Antioxidant activity of Caesalpinia sappan heartwood. Biol. Pharm. Bull. 2003, 26, 1534–1537. [Google Scholar] [CrossRef]
- Valcárcel, M. Principles of Analytical Chemistry: A Textbook; Springer Science & Business Media: Berlin, Germany, 2012. [Google Scholar]
- Re, R.; Pellegrini, N.; Proteggente, A.; Pannala, A.; Yang, M.; Rice-Evans, C. Antioxidant activity applying an improved ABTS radical cation decolorization assay. Free Radic. Biol. Med. 1999, 26, 1231–1237. [Google Scholar] [CrossRef] [PubMed]
- Gupta, V.; Chandra, N.; Tari, V.; Kannan, K. A Sustainable Approach for the Green synthesis of Silver Nanoparticles Using Brassica oleracea sub sp. botrytis (L.) leaves and its Antibacterial Activity. Phys. Chem. Solids 2024, 25, 303–310. [Google Scholar] [CrossRef]
- Umesha, S.; Singh, P.K.; Singh, R.P. Microbial Biotechnology and Sustainable Agriculture. In Biotechnology for Sustainable Agriculture: Emerging Approaches and Strategies; Singh, R.L., Mondal, S., Eds.; Woodhead Publishing: Sawston, UK, 2018; pp. 185–205. [Google Scholar] [CrossRef]
- Li, Y.; Sun, S.; Pu, X.; Yang, Y.; Zhu, F.; Zhang, S.; Xu, N. Evaluation of Antimicrobial Activities of Seaweed Resources from Zhejiang Coast, China. Sustainability 2018, 10, 2158. [Google Scholar] [CrossRef]
- Chandrasekaran, M.; Senthilkumar, A.; Venkatesalu, V. Antibacterial and antifungal efficacy of fatty acid methyl esters from leaves of Sesuvium portulacastrum L. Eur. Rev. Med. Pharmacol. Sci. 2011, 15, 775–780. [Google Scholar]

| S. No. | Tests | Experimental Conditions | Results |
|---|---|---|---|
| 1 | Test for alkaloids (Wagner’s test) | Seaweed extract added with 2 mL of Wagner’s reagent | Reddish brown precipitates appeared |
| 2 | Test for glycosides (Fehling’s test) | 25 mL of dilute H2SO4 was added to 5 mL of seaweed extract and boiled, cooled, and neutralized with 10% sodium hydroxide, and then 5 mL of Fehling solution A and B were added | Red precipitate appeared |
| 3 | Test for phenolic compounds (ferric chloride test) | Seaweed extract was dissolved in 5 mL of distilled water. A few drops of neutral 5% ferric chloride solution were added | Dark green color appeared |
| 4 | Test for steroids and Terpenoids (Salkowski’s test) | Seaweed extracts were treated with chloroform and filtered. The filtrates were treated with a few drops of concentrated H2SO4, shaken gently, and allowed to stand. | Golden yellow color indicates the presence. |
| 5 | Test for carbohydrates (Benedict’s test) | 0.5 mL of filtrate, 0.5 mL of Benedict’s reagent were added. The mixture was kept in a boiling water bath for 2 min. | Reddish brown color appeared. |
| 6 | Test for resins | Solubility test: seaweed extract was dissolved in different solvents | The extract dissolves completely, which indicates the presence of resins |
| 7 | Test for saponin | Foam test: 5 mL of seaweed extract in a test tube. Shake vigorously for 30 s and let it stand for 10 min | Persistent foam for 10 min indicates the presence of saponins |
| 8 | Test for tannin | In total, 3 g of a seaweed powdered sample was boiled in 50 mL distilled water for 3 min on a hot plate. The mixture was filtered, a portion of the filtrate was diluted with sterile distilled water in a ratio of 1:4, and three drops of 10% ferric chloride solution were also added. | The appearance of a blue color indicates the presence of tannins |
| 9 | Test for flavonoids | Ferric chloride test: 2 mL of extract added with a few drops of FeCl3 solution | Formation of blackish green color indicates the presence of flavonoid |
| S. No. | Parameters | Results |
|---|---|---|
| 1 | Protein | 20.8% w/w |
| 2 | Flavonoids | 0.92% w/w |
| 3 | Tannins | 0.09% w/w |
| 4 | Total Ash | 37.4% w/w |
| 5 | Total fat | 2.25% w/w |
| 6 | Carbohydrates | 8.43% w/w |
| S. No. | Position | Volume | Vial | Sample ID | Active |
|---|---|---|---|---|---|
| >1 | 15.0 mm | 5.0 µL | 1 | ETHANOL | Yes |
| >2 | 38.3 mm | 5.0 µL | 2 | METHANOL | Yes |
| >3 | 61.6 mm | 5.0 µL | 3 | ACETONE | Yes |
| >4 | 84.9 mm | 5.0 µL | 4 | BENZENE | Yes |
| Samples | % of Inhibitions | IC50 Value (µg/mL) | |||
|---|---|---|---|---|---|
| 20 (µg/mL) | 40 (µg/mL) | 60 (µg/mL) | 80 (µg/mL) | ||
| Methanolic Extract Fraction One (NOS) | 22.38 ± 1.56 | 39.52 ± 2.76 | 63.81 ± 4.46 | 82.85 ± 5.79 | 47.91 |
| Ascorbic acid (Std) | 26.66 ± 1.86 | 48.09 ± 3.36 | 68.57 ± 4.79 | 87.14 ± 6.09 | 42.45 |
| Methanolic Extract Fraction One (HPS) | 22.50 ± 1.57 | 39.64 ± 2.77 | 63.21 ± 4.42 | 84.64 ± 5.92 | 47.61 |
| Ascorbic acid (Std) | 25.71 ± 1.79 | 47.85 ± 3.34 | 71.42 ± 4.99 | 88.92 ± 6.22 | 42.04 |
| Methanolic Extract Fraction One (ABTS) | 22.22 ± 1.55 | 44.22 ± 3.09 | 63.55 ± 4.44 | 82.44 ± 5.77 | 46.89 |
| Ascorbic acid (Std) | 25.77 ± 1.80 | 48.44 ± 3.39 | 66.66 ± 4.66 | 85.77 ± 6.01 | 43.28 |
| S. No | Treatment | Conc (µg/mL) | Absorbance 570 nm |
|---|---|---|---|
| 1. | HT-29 by untreated cells | - | 0.517 ± 0.05 |
| 2. | DBE treated | 50 | 0.495 ± 0.03 |
| 3. | 100 | 0.431 ± 0.02 * | |
| 4. | 150 | 0.401 ± 0.03 * | |
| 5. | 200 | 0.367 ± 0.02 ** | |
| 6. | 250 | 0.301 ± 0.02 ** | |
| 7. | 5-Fluoro uracil treated | 50 | 0.118 ± 0.01 *** |
| Tested Bacteria | Dose (50 µL) Sample | Std. (30 µL) | |||
|---|---|---|---|---|---|
| 1% | 2% | 3% | 4% | ||
| Escherichia coli | 2.00 ± 0.14 | 3.10 ± 0.21 | 4.60 ± 0.32 | 6.20 ± 0.43 | 7.60 ± 0.53 |
| Vibrio cholera | 0.60 ± 0.04 | 1.80 ± 0.12 | 2.90 ± 0.20 | 4.10 ± 0.28 | 6.40 ± 0.44 |
| Pseudomas aeruginosa | 1.00 ± 0.07 | 2.20 ± 0.15 | 3.60 ± 0.25 | 5.00 ± 0.35 | 6.70 ± 0.46 |
| Bacillus subtilis | 1.50 ± 0.10 | 2.60 ± 0.18 | 3.90 ± 0.27 | 5.10 ± 0.35 | 6.90 ± 0.48 |
| Klebsiella pneumonia | 0.80 ± 0.05 | 2.10 ± 0.14 | 3.20 ± 0.22 | 4.50 ± 0.31 | 6.60 ± 0.46 |
| Staphylococcus aureus | 1.70 ± 0.11 | 2.80 ± 0.19 | 4.20 ± 0.29 | 5.50 ± 0.38 | 7.40 ± 0.51 |
Disclaimer/Publisher’s Note: The statements, opinions and data contained in all publications are solely those of the individual author(s) and contributor(s) and not of MDPI and/or the editor(s). MDPI and/or the editor(s) disclaim responsibility for any injury to people or property resulting from any ideas, methods, instructions or products referred to in the content. |
© 2025 by the authors. Licensee MDPI, Basel, Switzerland. This article is an open access article distributed under the terms and conditions of the Creative Commons Attribution (CC BY) license (https://creativecommons.org/licenses/by/4.0/).
Share and Cite
Bharathi, D.S.; Raja, A.B.; Nachimuthu, S.; Thangavel, S.; Kannan, K.; Shanmugan, S.; Tari, V. Exploration of Bioactive Compounds, Antioxidant and Antibacterial Properties, and Their Potential Efficacy Against HT29 Cell Lines in Dictyota bartayresiana. Mar. Drugs 2025, 23, 224. https://doi.org/10.3390/md23060224
Bharathi DS, Raja AB, Nachimuthu S, Thangavel S, Kannan K, Shanmugan S, Tari V. Exploration of Bioactive Compounds, Antioxidant and Antibacterial Properties, and Their Potential Efficacy Against HT29 Cell Lines in Dictyota bartayresiana. Marine Drugs. 2025; 23(6):224. https://doi.org/10.3390/md23060224
Chicago/Turabian StyleBharathi, Durairaj Swarna, Andiyappan Boopathy Raja, Suganthi Nachimuthu, S. Thangavel, Karthik Kannan, Sengottaiyan Shanmugan, and Vinaya Tari. 2025. "Exploration of Bioactive Compounds, Antioxidant and Antibacterial Properties, and Their Potential Efficacy Against HT29 Cell Lines in Dictyota bartayresiana" Marine Drugs 23, no. 6: 224. https://doi.org/10.3390/md23060224
APA StyleBharathi, D. S., Raja, A. B., Nachimuthu, S., Thangavel, S., Kannan, K., Shanmugan, S., & Tari, V. (2025). Exploration of Bioactive Compounds, Antioxidant and Antibacterial Properties, and Their Potential Efficacy Against HT29 Cell Lines in Dictyota bartayresiana. Marine Drugs, 23(6), 224. https://doi.org/10.3390/md23060224

